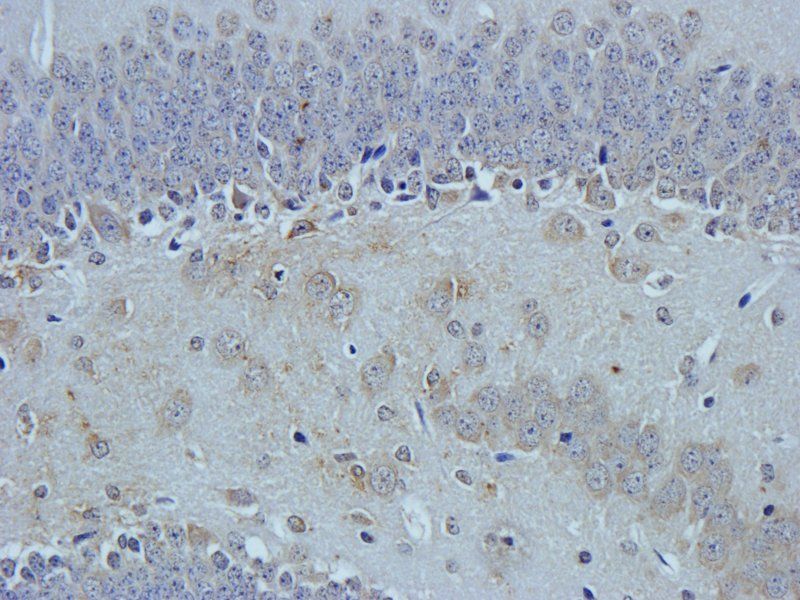
HEPCIDIN antibody

You have no items in your shopping cart.
All Products
- CtBP1 Rabbit Polyclonal Antibody [orb259602]
FC, ICC, IF, IHC, WB
Human, Mouse, Rat
Rabbit
Polyclonal
Unconjugated
100 μg - Emerin/EMD Rabbit Polyclonal Antibody [orb389401]
FC, ICC, IF, IHC, WB
Human, Mouse, Rat
Rabbit
Polyclonal
Unconjugated
100 μg - HnRNP L/HNRNPL Rabbit Polyclonal Antibody [orb389416]
ICC, IF, IHC, WB
Human, Mouse, Rat
Rabbit
Polyclonal
Unconjugated
100 μg FC, ICC, IHC, WB
Human, Mouse, Rat
Rabbit
Polyclonal
Unconjugated
100 μg- CD166/ALCAM Rabbit Polyclonal Antibody [orb18529]
FC, IF, IHC, WB
Human, Mouse, Rat
Rabbit
Polyclonal
Unconjugated
100 μg - PPID Mouse Monoclonal Antibody [orb507559]
FC, ICC, IF, IHC, WB
Human, Monkey, Mouse, Rat
Mouse
Monoclonal
Unconjugated
100 μg - Featured
HEPCIDIN antibody [orb315547]Featured
ELISA, IHC-P, WB
Human, Mouse, Rat
Rabbit
Polyclonal
Unconjugated
1 mg, 100 μg - Featured
CD86 Antibody [orb388891]Featured
IF, IHC, WB
Human, Mouse, Rat
Mouse
Monoclonal
Unconjugated
20 μg, 100 μg, 100 μg (without BSA and Azide) - Featured
GPx-4 Rabbit Polyclonal Antibody [orb340797]Featured
IF, IHC, WB
Human, Mouse, Rat
Rabbit
Polyclonal
Unconjugated
50 μl, 100 μl, 200 μl, 30 μl - Red Fluorescent Protein Antibody [orb334992]
IEM, IF, IHC-Fr, IHC-P, WB
Goat
Polyclonal
Unconjugated
100 μg